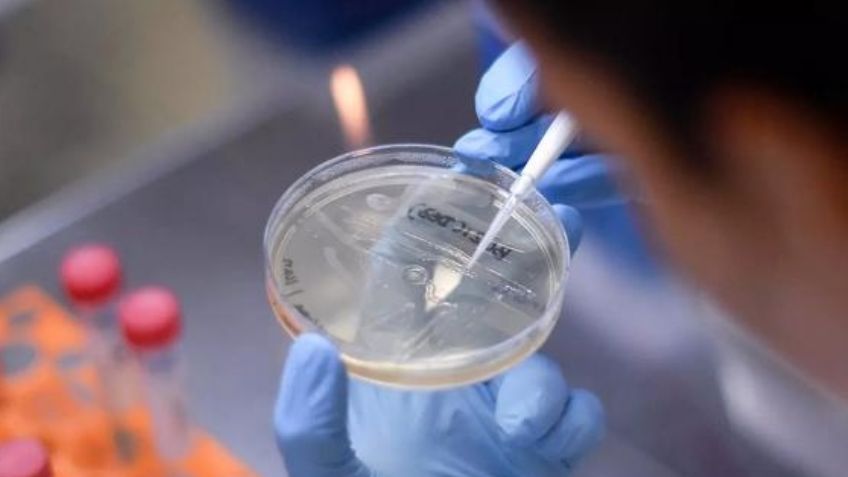
Advierte la OMS que seguirán apareciendo variantes de Covid-19 que "serán problemáticas"

Ciudad de México.- La salud mundial se vio amenazada hace más de un año a partir de que surgió el coronavirus, no obstante, después se desprendieron variantes que, una vez más, sembraron inquietud entre los expertos.
Da clic aquí y descubre más información de Tribuna Sonora en nuestra página de Google News
En la lista de mutaciones se consideran la británica B. 1.1.7, la brasileña P.1, y la más reciente, delta plus, por mencionar algunas. De acuerdo con el doctor David Nabarro, enviado especial de la Organización Mundial de la Salud (OMS), aparecerán más.
Por la mañana de este miércoles, el profesional conversó con la cadena británica Sky News. Durante su discurso, explicó que las ramificaciones de Covid-19 no cesarán y habrá casos en los que interfieran con el efecto de las vacunas.
Van a seguir viniendo. Iremos de Delta a Lambda y luego a las otras letras griegas. Eso es inevitable, y algunas de estas variantes serán problemáticas, podrán romper la protección relacionada con la vacuna en algunas personas".
En este sentido, la multiplicación de la enfermedad será problemática, es por eso que los trabajadores del área médica deberán actuar con celeridad para combatirlas.
Tenemos que recogerlas rápido, tenemos que movernos rápidamente si las vemos en una ubicación determinada, tenemos que construir la gestión de variantes, en lo que llamamos nuestra estrategia 'Covid Ready', que va a ser el patrón para el futuro previsible", finalizó.
Fuente: 20 Minutos